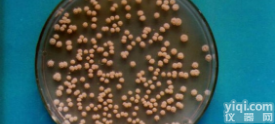
人<em>甲状腺</em>乳头状<em>癌细胞</em>株TPC-1

SW579[SW 579,SW-579]细胞株:人甲状腺鳞癌细胞系无污染 货号:GD-C8820410
细胞来源:细胞主要来源ATCC、DSMZ、ECACC、RIKEN、INCell、promocell、ScienCell、ECACC、JCRB、KCLB、Asterand、ICLC以及少数国外大学建系
产品包装:复苏形式:T25培养瓶(一瓶)或冻存形式:1ml冻存管(两支)
公司主营ATCC、DSMZ、RIKEN、ScienCell、INCELL、Promocell、ECACC、JCRB、KCLB、Asterand、ICLC以及少数国内外大学来源细胞系及原代细胞,全程提供细胞系背景、生长特性、来源、器官、类型、形态、培养条件、应用、系、疾病、组织、冻存条件、传代方法等复苏及冻存说明书信息,我们拥有丰富的细胞系培养经验,能提供细胞培养全方位的技术支持,让您实验再无烦扰!公司由在国外工作和学习多年的留学人员创办,由国内ZG科学院上海生物化学与细胞生物学研究所,复旦大学,同济大学等多名工作在线的细胞培养专家,提供细胞培养技术支持。公司依靠自身一些过硬的技术和理念,以世界的技术支撑阵容,提供一系列细胞相关的技术服务。为ZG的生命科学事业赶超欧美,提供了重要的基石;公司将依靠自主研究开发的高技术高质量和有的价格竞争力的产品,立足国内,面向世界。力争打破国外大公司在细胞培养科学领域接近垄断的地位,为ZG在生命科学的这一领域占领一席之地。公司筹划未来三年内,在沈阳、济南、北京、西安、宁夏、武汉、重庆等国内代表城市建立细胞培养分实验室,以便更好的服务国内广大医院、大学、制药企业等,你们的每一份关心和支持,都是我们前进的动力!
产品规格:≥1*10(6)/ml
安全级别:1
物种来源:人源或鼠源等
细胞形态:上皮细胞样/成纤维细胞样/淋巴母细胞样等
体内细胞培养及其操作步骤:【瘤细胞悬液接种】1)无菌选取生长良好(有光泽,淡红色)瘤组织或对数生长期培养瘤细胞;2)在PBS中将瘤组织剪碎后用匀浆器研磨,经80~100目筛网过滤成细胞悬液;3)培养细胞应用PBS洗两遍;4)计数并调整细胞浓度至107~108/ml;5)常规消毒后,于接种部位(通常为背部或腋窝腹股沟皮下)用医用注射器皮下潜行一段后注入细胞悬液(0.1ml/部位,>106细胞)。初次接种成功率低,细胞数尽可能多一些;6)次日注意观察动物一般情况。初次接种一般有一段较长的潜伏期,以后随着传代潜伏期逐渐缩短,固定为一个相对稳定的时间。【腹水瘤的建立与腹水瘤的接种】将实体瘤细胞直接种于小鼠腹腔、腹壁或其他部位,引起腹水,腹水中含有瘤细胞,将这种腹水反复传代,即可成为腹水瘤。初次传代时,腹水常呈血性(含大量红细胞),反复传代后腹水逐渐变成乳白色。腹水瘤的接种过程如下。1)将冻存或培养的腹水瘤细胞离心和洗涤,进行细胞计数;2)消毒动物,左下腹穿刺接种106腹水瘤细胞;3)接种腹水瘤细胞后约7~12d,待小鼠腹部明显膨大。用碘酒棉球消毒小鼠腹部,用9号针头抽取腹水,也可行腹部解剖后,用滴管吸取。每只小鼠可抽3~5ml;4)抽取的腹水经3000rpm离心15min,收集上清,分装冻存备用。
细胞特性:贴壁/悬浮等
细胞检测:细胞不含有HIV-1、HBV、HCV、支原体、细菌、酵母和真菌等污染物
培养条件:详见细胞说明书
传代方法:建议1:2-1:3传代;两天换液一次(具体详细询问公司细胞培养专家)
7-Nitro-1,2,3,4-tetrahydroisoquinoline hydrochloride, 97+%
9,10-Bis(phenylethynyl)anthracene
4-METHYLBENZYL MERCAPTAN
Salicylic acid
Dichloroacetonitrile
4-HYDROXY-CYCLOHEXANECARBOXYLIC ACID ETHYL ESTER
p-Terphenyl
1-Ethynylcyclohexanol
2,3-Dimethylhexane
Benzyl 4-(aminomethyl)tetrahydro-1(2H)-pyridinecarboxylate, 97%
2-(2-Diethylaminoethoxy)ethyl 1-phenylcyclopentanecarboxylate citrate
Tetrasodium pyrophosphate
trans-1,4-Diaminocyclohexane
(R)-(-)-2-HEXANOL
CesiuM fluoride
3-(ChloroMethyl)-5-(3,5-diMethylisoxazol-4-yl)-1,2,4-oxadiazole
4,4'-DiMethoxy-2,2'-bipyridyl
Methyl 3-broMo-5-hydroxybenzoate
Zinc oxide, ACS reagent
StrontiuM Carbonate, Powder, Reagent
2-Fluoro-6-nitrotoluene
erythromycin stearate
2-Hydroxy-3-nitropyridine
Z-L-methionine
1-(4-fluorophenyl)-2-thiourea
2-Amino-3-hydroxypyridine
3-Phenoxybenzoic acid
2-Hydroxypyridine
BariuM tetracyanoplatinate(II) tetrahydrate, PreMion|r, 99.99% (Metals basis)
1,3-DiMethyluracil-5-carboxaldehyde, 96%
4,4,4-Trifluorobutyric acid
Tirofiban hydrochloride Monohydrate
RUTHENIUM (III) BROMIDE
Octyl 4-MethoxycinnaMate
Benzocyclobutene
(+)-α-Funebrene
(2-imidazo[1,2-a]pyridin-2-ylethyl)amine(SALTDATA: 2.18HCl 0.1H2O)
2-Bromo-4-fluoroanisole, 98%
Methyl 1-Methylpyrrole-2-acetate
(S)-(+)-DBD-Py-NCS [=(S)-(+)-4-(N,N-Dimethylaminosulfonyl)-7-(3-isothiocyanatopyrrolidin-1-yl)-2,1,3-benzoxadiazole] [for HPLC Labeling]
4-(Hydroxymethyl)phenoxyacetic acid
2-NITROANILINE-4-SULFONIC ACID SODIUM SALT
1,4-DIMETHYLNAPHTHALENE
1-Methyl
1-(2-BroMophenyl)-1H-pyrazole
4-AMinopiperidine
6-Hydroxy-2-naphthaldehyde
7-Chloro-4-hydroxy-2-trifluoroMethylquinoline
[3-(4-MorpholinylMethyl)phenyl]MagnesiuM broMide, 0.25M solution in THF, AcroSeal
Platinum
N-(tert-Butoxycarbonyl)-L-phenylalaninol
2,4-di-tert-butylphenyl 3,5-di-tert-butyl-4-hydroxybenzoate
Sodium trimethylsilanolate
2-ethylhexyl 4-hydroxybenzoate
2,3,4,5-Tetraphenylthiophene
4-HYDROXY-4-PHENYLPIPERIDINE
4-Methoxy-2-naphthylaMine p-toluenesulfonate salt
3-Butyn-2-ol
6-ChloropyriMidin-4(3H)-one
2-(Trifluoromethyl)phenylglycine 97%
4-Methyl-2-pentene (cis- and trans- mixture)
pseudo-Pelletierine
1-Chloro-5-fluoro-2-methoxy-4-nitrobenzene
N-(2-Hydroxyethyl)-N-methylaniline
Flavoxate hydrochloride
MERCURY
Poly(diallyldimethylammonium chloride)
2-Methylbutyl isothiocyanate
1-BroMo-4-chloro-2-nitrobenzene
Isobutyl Myristate
Methyl 3-iodo-1H-indole-2-carboxylate
N-MethylbenzylaMine, 97%
1-NAPHTHYL PHOSPHATE MONOSODIUM SALT MONOHYDRATE
ShikiMic Acid
Valerian oil
4-methoxy-2-nitro-1-(trifluoromethyl)benzene
L-Phenylalanine methyl ester hydrochloride
N-Benzoyl-L-tyrosine Ethyl Ester
Porcine Relaxin,RLN ELISA Kit
S100 ELISA Kit
PCDHβ2 ELISA Kit
Human FNTα ELISA Kit
SPTAN1 ELISA Kit
Rat β2-microglobulin,BMG/β2-MG ELISA Kit
Chicken MIP-1β (Macrophage Inflammatory Protein 1 Beta) ELISA Kit
Human CCK8 ELISA Kit
Human CXCL9/MIG ELISA Kit
ALDH2 ELISA Kit
Aeromonas hydrophila Medium
O/F Medium
Acetylacetaldehyde diMethyl acetal, 90+%
Hydrogen fluoride pyridine coMplex, ca 70% HF
5,5-Diphenylhydantoin, 99%
2-Fluoro-4-(pentafluorothio)aniline, 97%
erythromycin stearate
cerium(4+) disulphate
ginsenoside rc
1,4-Dioxan-2,5-dione
Octyl-beta-D-glucopyranoside
2-Benzyl-2-(dimethylamino)-4'-morpholinobutyrophenone
1H-Pyrrolo[3,2-B]Pyridine-2-Carboxylic Acid
Lead(IV) oxide, 97%
L-Alanine benzyl ester p-toluenesulfonate, 98%
4-Nitrobenzenesulfonic Acid Hydrate
α-ChlorocinnaMaldehyde
PHENYLMAGNESIUM IODIDE
COBALT(II) PHTHALOCYANINE
1-MethylcyclopropaneMethanol
Ethyl 5-hydroxyindole-2-carboxylate
7-Bromo-1,1,2-trimethyl-1H-benzo[e]indole
3-Cyanobenzoic acid ,98%
10-Deacetylbaccatin III, from taxus baccata, 95%
Stearyl Acrylate (stabilized with MEHQ)